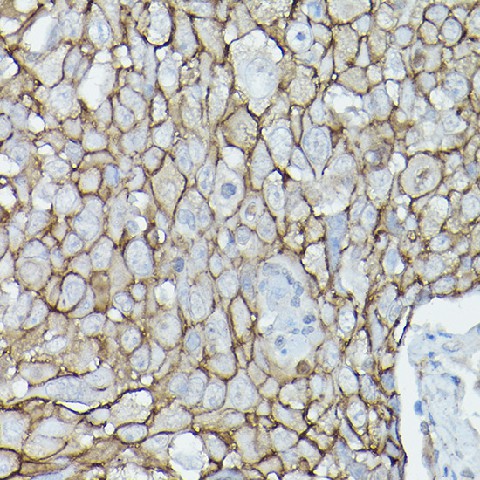
Валидация Elabscience E-AB-92353

| UNIPROT | O60716 |
| Иммуноген | Рекомбинантный гибридный белок из человеческого δ-Catenin/p120 Catenin |
δ-Catenin/p120 Catenin Polyclonal Antibody (E-AB-92353)
Реактивность подтвержденная:
человек
Источник (хозяин):
кролик
Валидировано для:
IHC
WB
Характеристики
Техническое описание
| Каталожный номер | E-AB-92353 |
| Название антигена | Catenin Delta 1 (CTNNd1) |
| UNIPROT | O60716 |
| Иммуноген | Рекомбинантный гибридный белок из человеческого δ-Catenin/p120 Catenin |
| Английские синонимы | CAS, CTNND, P120CAS, P120CTN, p120, Cadherin-Associated Protein Delta 1, Cadherin-associated Src substrate |
Реактивность подтвержденная Нужна другая реактивность? |
человек |
| Источник (хозяин) | кролик |
| Изотип | IgG |
| Клональность | поликлональное |
| Рекомбинантное | нет |
| Готовое к использованию | нет |
| Концентрация | 1мг/мл |
| Конъюгат | нет |
| Валидировано для | IHC WB Иммуногистохимия; Вестерн-блоттинг |
| Рекомендуемые разведения | WB 1:500-1:2000; IHC 1:50-1:200 |
| Метод очистки | Аффинная хроматография |
| Состав буфера | PBS с 0.02% азид натрия,50% глицерин,pH7.3 |
| Условия доставки | термобокс с аккумуляторами холода |
| Условия хранения | Хранить при -20°C - 12 месяцев. Избегать повторяющихся циклов замораживания/оттаивания |
| Срок хранения | 12 месяцев |
| Производитель | Elabscience |
| Ссылка на страницу товара на сайте производителя | https://www.elabscience.com/p-δ_catenin/p120_catenin_polyclonal_antibody-e_ab_92353 |
|
Артикул
|
Наименование |
Производитель
|
|---|
|
Артикул
|
Наименование |
Производитель
|
|---|
|
Артикул
|
Наименование |
Производитель
|
|---|
|
Артикул
|
Наименование |
Производитель
|
|---|
|
Артикул
|
Наименование |
Производитель
|
|---|
Акции и предложения
Популярные продукты:
Mouse Desmin(DES) ELISA kit (E03D0282)
Организм: мышь
ELISA Kit DIY Materials for Permeability Glycoprotein (Pgp) (KSB690Hu01)
Организм: человек
Диапазон определения: 0.312-20 нг/мл
Чувствительность: 0.121 нг/мл
Диапазон определения: 0.312-20 нг/мл
Чувствительность: 0.121 нг/мл
Canine Valproic Acid ELISA kit (E08V0432)
Организм: собака
Sheep Coactosin like protein(COTL1) ELISA kit (E14C1959)
Организм: овца
Rat Coactosin like protein(COTL1) ELISA kit (E02C1959)
Организм: крыса